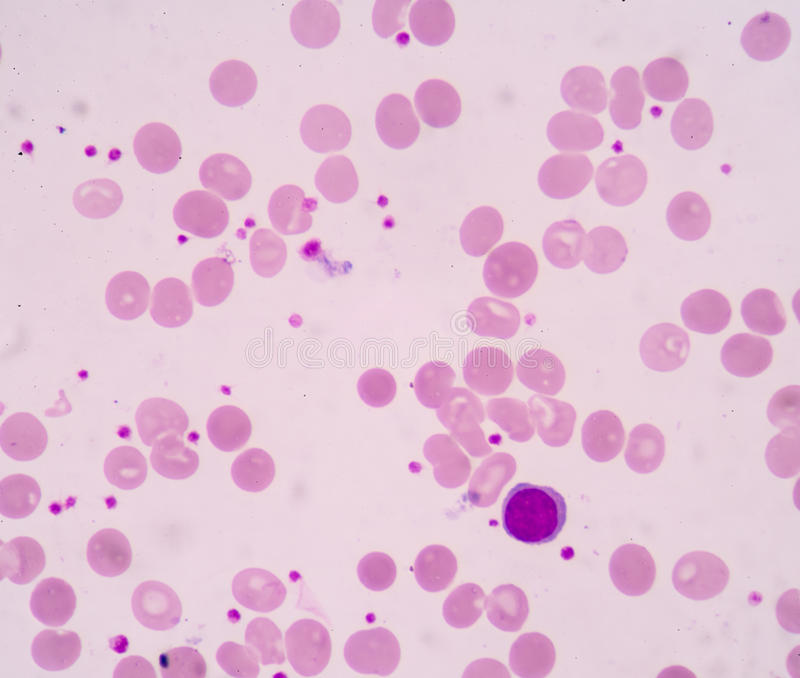

动漫白细胞是一场展现心灵与美景的奇妙之旅。在这部作品中,观众将跟随白细胞的冒险历程,探索其内心的世界和外在环境的美丽。通过精彩的情节和细腻的画风,动漫将带领观众领略壮丽的自然景色和富有想象力的奇幻场景,同时展现角色的情感变化和成长历程。这是一场充满惊喜和感动的旅程,让人陶醉其中,流连忘返。
在动漫的世界里,有一群特殊的角色总是牵动着我们的心弦,那就是白细胞,他们不仅在虚构的战场上英勇战斗,对抗那些威胁世界的敌人,更是我们心灵的守护者,让我们跟随动漫白细胞的脚步,踏上一段探索自然美景的旅行,寻找内心的平静与宁静的力量。
启程:远离尘嚣,心灵重生
在一个阳光明媚的清晨,我们背起行囊,追寻心中的指引,开始了这场远离喧嚣的旅行,动漫中的白细胞形象如同我们的精神支柱,引领我们走向未知的世界,探索自然的美景。
自然美景的探索,心旷神怡
沿途的风景如画,青山绿水、蓝天白云,一切都显得如此宁静而美好,我们漫步于林间小道,徒步走过蜿蜒的溪流,感受着大自然的魅力,每一处风景都如同一幅精美的画卷,令人心旷神怡,在这之中,我们不禁想起动漫中的白细胞们,他们面对困难时勇往直前、毫不退缩,他们的坚韧与勇气,让我们也充满了力量,同样,面对大自然的美景,我们也学会了勇敢面对生活中的挑战。
发现内心的平静,宁静致远
当我们沉浸在这片美景之中,心中的纷扰渐渐消散,只剩下宁静和平和,我们意识到,真正的幸福并不在于追求物质的满足,而在于心灵的宁静与满足,动漫中的白细胞们在战斗中学会寻找内心的平静,这种平静让他们更加坚定地走下去,战胜一切困难,我们也一样,在探索自然美景的过程中,学会了放下心中的包袱,找到真正的自我。
幽默元素增添乐趣,欢乐无限
这次旅行充满了幽默与欢乐,我们在林间小道上遇到了各种有趣的小动物,它们或呆萌或机灵,总能带给我们欢笑,这些欢乐时刻,让我们忘记了旅途的疲惫,更加期待未来的探险。
鼓舞人心,踏上心灵之旅
这次动漫白细胞引领的自然美景之旅,让我们不仅欣赏到了大自然的美丽风光,更学会了勇敢面对生活中的挑战,找到了内心的平静与宁静的力量,我们意识到,人生就像一场旅行,总会有坎坷和困难,但只要我们保持勇气和坚韧,就能战胜一切,我们鼓励每一个读者踏上自己的旅程,去探索那些未知的美景,寻找内心的平静,在这个过程中,我们或许会遇到困难与挑战,但只要我们保持勇气和坚韧,就一定能找到属于自己的幸福。
让我们一同踏上这场心灵之旅,跟随动漫白细胞的脚步,探索自然美景,领略大地的壮丽,发现内心的平静与宁静的力量,这是一场充满乐趣、鼓舞人心的旅程,让我们一起勇往直前,追寻内心的梦想与幸福。